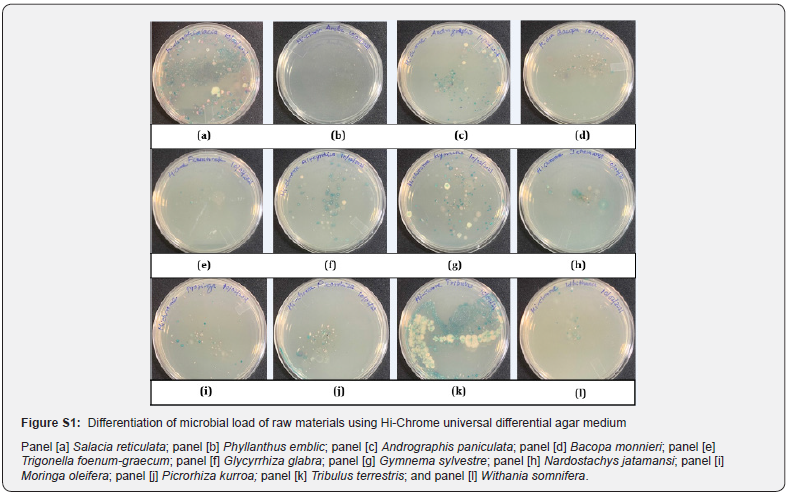
Click here to view Large Figure 2

Evaluation of Microbial Load of Herbal Raw Materials: a Necessary Quality Control Measure to Ensure Safety of Finished Herbal Preparations
Rajkumar Dattatraya Bhosale and Sriram Padmanabhan*
Herbal Division, Sava Healthcare Limited, Research Center, India
Submission:March 17, 2021; Published: April 29, 2021
*Corresponding author: Sriram Padmanabhan, Herbal Division, Sava Healthcare Limited, Research Center, Block D1, Plot No. 17/6, MIDC, Chinchwad, Pune-411019, India
How to cite this article: Rajkumar Dattatraya B, Sriram P. Evaluation of Microbial Load of Herbal Raw Materials: a Necessary Quality Control Measure to Ensure Safety of Finished Herbal Preparations.Adv Biotech & Micro. 2021; 16(2): 555934 DOI:10.19080/AIBM.2021.16.555934
Abstract
Background: Selection of herbal raw material plays a vital role in developing herbal medicines. Various factors that affect the quality of herbal raw material include storage conditions, humidity, microflora and hygiene status of the people handling them. Various microorganisms that contaminate the herbal raw material be it roots, leaves, stems, rhizomes include pathogenic fungi, Gram positive and gram negative bacteria.
Method: We describe a simple and an effective method that involves extraction of microbes from the herbal raw material pulverized powder within 10 minutes and estimation of microbial counts by conventional plating method and using Soleris®.
Findings: Various types of organisms identified in different plant materials using Hi-Chrome Agar include Klebsiella, Salmonella and Pseudomonas Spp and some plant materials showed the presence of Proteus and Enterococcus Spp. The microbial load represented as cfu/g of various plants tested in this paper supports the reported values estimated by other methods.
Interpretation: A simple, rapid and a cost-effective method for estimation of microbial load in herbal raw materials is described for the first time. The method
Keywords: Raw material; Liquorice; Phytomedicines; Hi-Chrome Agar; Soleris®
Introduction
Herbal medicines also called as botanical medicines or phytomedicines refers to herbs, herbal materials, herbal preparations, and finished herbal products that contain parts of plants or whole plant as active ingredients for the betterment of health in humans [1]. Although the use of herbal drugs dates back to nearly 60,000 years, in the last decade, the interest and emphasis on the use of herbal medicines has increased due to observed drug resistance of infectious pathogens against used antimicrobial agents and also due to considerable side effects of the used synthetic drugs and their cost of treatment [2]. Nearly 80% of people worldwide rely on herbal medicines for some part of primary healthcare and such Complementary and Alternative Medicines (CAMs) are becoming popular in countries such as UK, rest of Europe, as well as in North America and Australia [3]. Although, the use of herbal extracts as drugs and health supplements have shown promising potential to treat human diseases with the efficacy of a good number of herbal products clearly established, many of them remain untested and not monitored adequately due to lack of suitable quality controls etc. [4].
The microbial contamination in herbal products could be due to microbes coming from leaves, stems, flowers, seeds, roots, rhizhomes from which herbal extracts are prepared. Since the plant materials are procured in tonnes, sometimes merely doing microbial estimation in end products cost heavily for the manufacturing plants, hence estimation of microbial load in raw materials is a critical parameter to define the quality of raw material to be used for manufacturing of extracts. This will minimize wastage of time and cost and make the COGS attractive for all markets. Also, during handling and processing the raw material can get contaminated with airborne bacterial and fungal pathogens; hence there is a need to verify the presence of bacterial and fungal pathogens to avoid the health risk during drug development.
The presence of endophytic microorganisms particularly bacteria and fungi in medicinal plants are reported to enhance the production of pharmacologically active secondary metabolites [5]. However, some of the microbes also contaminate the raw material and create problem in developing herbal drugs. Some of the contaminating pathogens include fungi such as Alternaria alternata, Fusarium solani, Colletotrichum gloeosporioides, Zythiostroma pinastri, Phomopsis elaeagni, Verticillium dahlia, Cercospora traversiana and Puccinia coronate [6] while the most commonly isolated bacteria from the herbal medicines include S. aureus (49.2%), Salmonella spp. (34.8%), E. coli (25.8%), and P. aeruginosa (14.4%) making them unfit for consumption [7]. Fifteen bacterial contaminants have been identified in a selected medicinal plant in South Africa, the most recurrent being Pantoea sp. and five strains of Bacillus spp. (non-pathogenic) [8]. Nearly 80% of the population in developing countries use traditional herbal medicines as part of their primary health care [9-11]. The health status of elderly consumers are more affected by the presence of microbial contaminants in herbal products due to their immunocompromised conditions, hence steps to minimize such adverse events is critical. Most of the global consumers consider herbal products to be safe, although toxic heavy metals and microbial contamination in finished herbal products have been a concern [12]. The general guidelines of ayurvedic formulations as prescribed in ASU Pharmacopoeias have specified microbial limits with the total absence of Staphylococcus aureus, Salmonella Spp, Pseudomonas aeruginosa and Escherichia coli and the total microbial plate count (TPC) to be in the range of 105/g, 107/g (for topical use) and the total yeast & mold the count to be ~ 103/g. In the light of the above facts, we have attempted to evaluate microbial load in raw material stage by a simple method of extraction and report that the estimation of microbial load in herbal raw materials described is simple, sensitive, reproducible and applicable to all forms of the plant material and is robust. We also identified the types of bacteria that contaminate such raw materials so that removing them from the raw material can be thought of and also one could ascertain if the nature of such bacteria are pathogenic or non-pathogenic
Material and Methods
Reagents and Chemicals
NF-TVC vials were procured from NEOGEN, Lansing, USA and Soyabean Casein Digest Agar from HiMedia Laboratories, Mumbai, India. All other reagents were of analytical grade, unless mentioned otherwise.
Raw material collection
Commercially available raw materials of plant origin were procured from Production Unit, SAVA Healthcare Ltd., Malur, Karnataka, India. Different plant parts of medicinal plants were selected viz leaves, roots, rhizome, fruit rinds, fruits and whole plant based on the reported therapeutic value from different plants for the enumeration of microbial load.
Sample preparation for microbial analysis
The method followed is given in Figure 1. In brief, one gram of the finely ground raw material was suspended in 19 ml of sterile saline solution and mixed thoroughly by vortexing for 5-10 minutes. The resulting suspension was centrifuged at 2000 rpm at RT to remove debris of raw material and supernatant was used for microbial analysis.
Microbial analysis by conventional plating method
The Total Viable Count (TVC) in the supernatant was determined by conventional method using pour plate technique as per standard US FDA BAM method [13]. Briefly, one ml of supernatant was transferred to 9 ml of sterile saline solution in screw capped tubes and mixed well by vortexing to get 101 dilutions. One ml of the previous dilution was transferred to fresh 9 ml sterile saline solution to obtain 102 dilutions. Likewise, supernatant was diluted up to 106 dilutions. One ml of each dilution was transferred aseptically to separate sterile petri plates and 20-25 ml of molten sterile soybean casein digest agar was poured. Agar plates were allowed to solidify and then incubated at 35 °C for 48 h. After incubation, plates were observed for colonies and the numbers of colonies were counted to enumerate microbial load (cfu/gm) of raw material.
Microbial analysis by Soleris®
One gram finely ground raw material was suspended in 9 ml of sterile saline solution and mixed thoroughly by vortexing for 5 -10 minutes and then centrifuged at 2000 rpm to remove debris of raw material and supernatant was used for microbial analysis using Soleris® Instrument, Lansing, USA. The dilutions were prepared by adding 1 ml of supernatant to 9 ml of sterile saline solution and similarly further dilutions were prepared up to 107. NF-TVC vials were used for enumeration of microbial load. 1 ml of each dilution was inoculated separately in TVC vials and incubated at 35 °C in Soleris® for 24 h as per protocol given by manufacturer.
Bacterial identification using Hi-Chrome Agar and method followed
Hi-chrome universal differential medium is used for presumptive identification of various groups of bacteria on the basis of color developed by their colonies.
One gram finely ground raw material suspended in 9 ml of saline solution and mixed by vortexing for 5-10 minutes. 50 μl of the suspension transferred in sterile petri plate and 20-25 ml of molten sterilized Hi-chrome universal differential agar medium poured in petri plates. The agar medium was allowed to solidify and then incubated at 35 °C for 18-24 h. After incubation, agar plates were observed for different colored colonies.
Results and Discussion
Figure 1 depicts the flow chart for processing of the herbal raw materials for enumeration of microbial load. Table 1 shows the herbal plants used in the study along with the plant parts that contain the active constituents for the therapeutic or nutritional value demonstrated by earlier researchers. To ensure that our described processing method does not underestimate the microbial load, we took two herbal samples namely Salacia reticulata roots and whole plant of Tribulus terristris and tested the microbial load by conventional plating method. The results indicated that irrespective of the time of extraction, the microbial values (cfu/g) remain the same. Hence for all further experiments we adhered to using 10 minutes extraction time (Table 2). For the evaluation of microbial contamination in randomly selected 12 raw materials, the total number of viable bacterial colony-forming units per gram (cfu/g) were determined (Table 3) by conventional plating method and also by using the Soleris® system from the material processed as shown in Figure 1. As evident from Table 3, the cfu values/g of the pulverized raw material is similar when tested by either of the methods.




Also, we compared our microbial load values obtained for some of the raw materials with the values reported in the literature (Table 4). It is clear that for Salacia, Moringa, Glycyrrhiza, Nardostachys, Withania, Andrographis, Trigonella raw materials, our cfu/g values match the values reported by other workers indicating that the described method for estimation of microbial load in herbal raw materials is fast, robust and reproducible [14- 17]. The organisms that have been identified from all the 12 raw materials are shown in supplementary Figure S1. At the end of the incubation period, pathogenic bacterial isolates were preliminarily characterized by colony morphology, Gram staining, and Hi Chrom agar. Hi-Chrome universal differential medium is employed for presumptive identification of various groups of bacteria on the basis of color developed by their colonies. These colors of colonies are developed due to reactions of genus or species specific enzymes with the two chromogenic substrates incorporated in the medium. While Enterococci spp. produces a ß-glucosidase enzyme that cleaves the chromogenic substrates resulting in the formation of bluish colonies, Escherichia coli produces ß-galactosidase which specifically cleaves the other chromogenic substrate resulting in the formation of purple-colored colonies. The peptone in the medium is the source of aromatic amino acids like phenylalanine and tryptophan that can be utilized by bacteria of genus Proteus, Providencia and Morganella, exhibits deaminase activity which results in the formation light pink to brown colored colonies. The Salmonella genus does not utilize any of these substrates, hence appear colorless while Staphylococcus appear golden yellow. Table 4 gives the various types of organisms identified in all the 12 extracts tested in this study.

Microbial contamination in pharmaceuticals cause changes in their physical characteristics like turbidity or deposit, and changes in odor and color and also its quality like breaking of emulsions, thinning of creams, fermentation of syrups etc. Hence, bioburden which is the total number of microorganisms present on a product prior to sterilization and its estimation in raw materials and finished pharmaceutical products determines if the product complies with the requirements of the US Pharmacopeia. While such aspects are well recognized in allopathic medicines, there is currently no practice in estimation of bioburden in herbal raw materials and hence this article disclosing the significance of such estimation assumes critical importance. Herbal raw materials such as spices require strict control to prevent spoilage, the major causes of spoilage being improper handling, growth of spoilage microorganisms, action of naturally occurring enzymes, chemical reactions and structural changes during storage [18]. The presence of fungi in herbal preparations under certain conditions may lead to the secretion of toxic metabolites such as mycotoxins, which when ingested, inhaled, or absorbed through the skin cause illness or human and animal death [19] Table 5.

WHO mentions that bacterial colony counts for medicinal plant materials intended for internal use, should not exceed 105 cfu/g while plant products intended for topical use should not exceed 107 cfu/g [10]. The limits of bacterial contamination given in European pharmacopoeia as reported by Okunlola et al. [20] are total aerobic bacteria (105 cfu/g), Enterobacteria and other Gram-negative organisms (103 cfu/g). Although many of the plant materials are below the prescribed limits, what appears important to understand that in many cases, these organisms will be carried forward to the extract and then the extract will be loaded with microbes which will be finally not suitable for human use.
The method followed by Vuuren et al. [8] for estimation of microbial load in herbal raw materials is lengthy. The steps include weighed plant sample in a beaker containing a measured volume of sterile water and such a samples is then agitated on a shaking incubator at 37 °C at 104 rpm for 1 h and then used for plating [8]. Our method involves merely 5 minutes vortexing and after a brief spin is ready for analysis. Hence, our method is simpler where the samples preparation does not take more than 10 minutes and the results are reproducible.
Agarwal et al. [21]. have attempted similar estimation but have carried out washing of the roots of licorice with water to remove dust and other contaminants. Later these washed materials were dried at 45 °C before taking for analysis. We have not done any such treatments and yet we are able to get values of TVC similar to what is reported [17]. The authors have observed variations in total microbial count from 104 /g to 107 /g based on regions from where they are procured. Our results on observations of presence of Pseudomonas, E. coli, Salmonella in Moringa are in conformity with the findings of Walia et al. [22] in a recent report where impact of such pathogens on infant diet for undernourished children has been debated. Also, bacteria such as Klebsiella, Pseudomonas have been seen in Withania somnifera tissue cultures by Kulkarni et al. [23] as seen by us in the raw material of Withania reported in this study.
There are extrinsic and intrinsic factors that determine the microbiological quality of medicinal plants. While the intrinsic factors include the inherent antimicrobial agents present in the plant and certain beneficial microbial content for plant survival and growth, the extrinsic factors such as humidity, harvest method, post harvesting treatment, packaging and storage conditions dictate the extent and nature of microbial contaminants [24]. Since in some plants such microbial contaminations affect the concentration of active constituent available in such plants [21], it becomes imperative that accurate estimation of microbial load in raw material itself would become a crucial factor for achieving purer herbal extracts with maximum therapeutic potential.
This is the first report of a method that determines the estimation of microbial load in herbal raw materials and opens up a potential possibility of using the same as a QC releasing parameter before taking up for processing for preparation of herbal extracts. Medicinal plants, used as raw materials, for production of herbal extracts for their use as food supplements and herbal medicines, may have quality and safety issues due to deposition of fungicides, pesticides and other microorganisms in them. Since globally the herbal drugs are in high demand for primary health care purposes due to their minimal side effects, their usage is preferred over modern medicines that have adverse side effects, synthetic in nature and whose long-term side effects are unknown and in several cases are expensive [25].
The global herbal medicine market size is expected to reach US$ 550 billion by 2030 as per the recent survey by Globe Newswire. Hence, it is obvious that the demand of herbal medicines is for their therapeutic value to treat disease as well as a type of dietary supplement for enhance general health and wellbeing is increasing substantially. Several herbal extracts find their use in treatment of various diseases and disorders viz. acne vulgaris [26], hypertension [27], hyperlipidemia [28], diabetes [29], cancer [30], erectile dysfunction [31], kidney [32] to name a few. Interestingly, the synergistic effect of herbal medicines with available antimicrobial agent has been studied to overcome drug resistance in several pathogens such as Staphylococcus aureus, Staphylococcus epidermidis, Cutibacterium acnes, Pseudomonas aeuroginosa, Escherichia coli, Bacillus cereus and Klebsiella pneumoniae [33].
Bais et al. [34] report the presence of Escherichia coli, Staphylococcus aureus and P. aeruginosa in Withania extracts available in the market and conclude that the contamination is due to poor manufacturing practices and improper storage condition of formulations. Our results presented in this article, shows the presence of E. coli and Pseudomonas in the raw material of Withania somnifera itself indicating that the source of such organisms is the raw material and strictly not due to the manufacturing processes adopted. The microbial load in raw materials can affect the quality and efficacy of herbal medicines. So, there is a need to assess the microbial load in early stage of development of herbal medicines. In this study, microbial load of several plant materials was analyzed by conventional method and Soleris® instrument. This comparative data would be helpful to select the raw material on the basis of microbial load so that it wouldn’t create problem in latter stage of herbal drug development. This is the first report on the use of Soleris® for enumeration of microbial load of herbal raw materials directly and would be useful both for food and pharmaceutical industry.
Recent work by Silviera et al. [35] and Safa et al. [36] suggest that several herbal medicines have potential use as adjuvants in the treatment of early/mild common flu healthy adults and also in the context of COVID-19 patients. Hence, any method that would help to generate quality herbal extracts would be of immense use from clinical viewpoint and in the light of this our present article is relevant to the possible additional benefit to human subjects suffering from the current ongoing COVID pandemic. Due to the immunocompromised conditions, presence of unwanted microbes in herbal preparations creates a concern of safety of consumers of herbal products and hence this aspect needs urgent attention, especially in consumers of elderly populations. Taking these facts into consideration, we believe that regulatory agencies should come forward and take the necessary measures to ensure the safety of finished herbal preparations and encourage manufactures to adapt the analysis of microbial load in herbal raw material as a routine quality check parameter/specification.
Acknowledgement
The authors wish to thank the Purchase team of SAVA Healthcare Limited for supply of raw materials of all the plants used in this study. Thanks, are also due to Mr. Vinod Jadhav, Chairman SAVA Healthcare Limited and Mr. Avinaash Mandale, MD, SAVA Healthcare Limited for their constant support and encouragement.
References
- Pan SY, Litscher G, Gao SH, Zhou SF, Yu ZL, et al. (2014) Historical perspective of traditional indigenous medical practices: The current renaissance and conservation of herbal resources. Evid-Based Complementary Altern Med 2014: 525340.
- Azimi H, Fallah Tafti M, Khakshur AA, Abdollahi M (2012) A review of phytotherapy of acne vulgaris: Perspective of new pharmacological treatments. Fitoterapia 83 (8): 1306-1317.
- Anquez-Traxler C (2011) The legal and regulatory framework of herbal medicinal products in the European Union: a focus on the traditional herbal medicines category. Drug Inf J 45(1): 15-23.
- Raynor DK, Dickinson R, Knapp P, Long AF, Nicolson DJ (2011) Buyer beware? Does the information provided with herbal products available over the counter enable safe use? BMC Med9: 94.
- Ludwig-Muller J (2015) Plants and endophytes: equal partners in secondary metabolite production? Biotechnol Lett 37(7): 1325-1334.
- Abtahi F, Nourani SL (2017) The most important fungal diseases associated with some useful medicinal plants. © Springer International Publishing AG M Ghorbanpour, A Varma (eds.), Medicinal Plants and Environmental Challenges.
- De Sousa Lima CM, Fujishima MAT, de Paula Lima B, Mastroianni PC, de Sousa FFO, et al. (2020) Microbial contamination in herbal medicines: a serious health hazard to elderly consumers. BMC Complement Med Ther 20(1): 17.
- Vuuren SV, Williams VL, Sooka A, Burger A, Van der Haar L (2014) Microbial contamination of traditional medicinal plants sold at the Faraday muthi market, Johannesburg, South Africa. S Afr J Bot 94: 95-100.
- Umair M, Altaf M, Abbasi AM (2017) An ethnobotanical survey of indigenous medicinal plants in Hafizabad district, Punjab-Pakistan. Plos One 12 (6): e0177912.
- (2007) WHO guidelines for assessing quality of herbal medicines with reference to contaminants and residues.
- Yewale S, Farash Z, Kolhe S, Sakkan S, Bhope S, et al. (2020) Benefits of Soleris® over the conventional method for enumeration of microbial load in Salacia herbal extract. Polish J Microbiol 69(4): 453-462.
- Keter L, Too R, Mwikwabe N, Ndwigah S, Orwa J, et al. (2016) Bacteria contaminants and their antibiotic sensitivity from selected herbal medicinal products from Eldoret and Mombasa, Kenya. Curr Res Microbiol 7(1): 18-28.
- Ritter V, Kircher S, Sturm K, Warnd P, Dick N (2009) USDA FSIS, FDA BAM, AOAC, and ISO culture methods BD BBL CHROMagar Listeria Media. J AOAC Int 92(4): 1105-1107.
- Nur F, Libra UK, Rowsan P, Azad MAK, Begum K (2018) Assessment of bacterial contamination of dried herbs and spices collected from street markets in Dhaka. Bangladesh Pharma J 21(2): 96-100.
- Jha SV, Bhagwat AM, Pandita NS (2012) Pharmacognostic and Phytochemical studies on the rhizome of Nardostachys jatamansi DC. using different extracts. Phcog J 4(33): 16-22.
- Peles F, Győri Z, Bácskai T, Szabó ZS, Murvai M, Kovács B (2012) Microbiological quality of organic wheat grains and sprout. Analele Universităţii din Oradea, Fascicula Protecţia Mediului 18: 53-60.
- Patterson JE, Woodburn MJ (1980) Kleibsella and other bacteria on alfalfa and bean sprouts at the retail level. J Food Sci 45(3): 492-495.
- Devi TB, Dash SK, Bal LM, Sahoo NR (2016) Physicochemical and microbiological characteristics of ginger paste (cv. Suprabha) during storage in different packaging and temperature conditions. Cogent Food Agric 2 (1): 1223261.
- Pitt JI (1996) What are mycotoxins? Australian Mycotoxin Newsletter 7 (4): 1.
- Okunlola A, Adewoyin AB, Odeku AO (2007) Evaluation of pharmaceutical and microbial qualities of some herbal medicinal products in south western Nigeria. Trop J Pharmaceut Res 6(1): 661-670.
- Agarwal M, Rai V, Khatoon S, Mehrotra S (2014) Effect of microbial load on therapeutically active constituent glycyrrhizin of Glycyrrhiza glabra. Indian J Tradit Knowl 13(2): 319-324.
- Walia K, Kapoor A, Farber JM (2019) Qualitative microbiological risk assessment of Moringa oleifera leaf powder to be used to treat undernutrition in infants and children in Cambodia and India: A Review. Rev J Food Prot 82(3): 513-521.
- Kulkarni AA, Kelkar SM, Watve MG, Krishnamurthy KV (2007) Characterization and control of endophytic bacterial contaminants in in vitro cultures of Piper spp. Taxus Baccata subsp, wallichiana, and Wiathania somnifera. Can J Microbiol 53(1): 63-74.
- Amina RH, Eapen JK, Deepa MS (2017) Microbial evaluation of commercial samples of dried Amalaki (Phyllanthus emblica Linn.) fruit rind procured from Herbal drug market in Kerala, India. J Pharmacogn Phytochem 6(5): 286-288.
- Turkson BK, Mensah MLK, Sam GH, Mensah AY, Amponsah IK, et al. (2020) Evaluation of the microbial load and heavy metal content of two polyherbal antimalarial products on the Ghanaian market. Evid-Based Complement Altern Med 2020: 1014273.
- Chomnawang MT, Surassmo S, Nukoolkarn VS, Gritsanapan W (2005) Antimicrobial effects of Thai medicinal plants against acne-inducing bacteria. J Ethnopharmacol 101(1-3): 330-333.
- Tabassum N, Ahmad F (2011) Role of natural herbs in the treatment of hypertension. Pharmacogn Rev 5(9): 30-40.
- Visavadiya NP, Narasimhacharya AVRL (2011) Ameliorative effects of herbal combinations in hyperlipidemia. Oxid Med Cell Longev 2011: 1-8.
- Modak M, Dixit P, Londhe J, Ghaskadbi S, Devasagayam TPA (2007) Indian herbs and herbal drugs used in the treatment of diabetes. J Clin Biochem Nutr 40(3):163-173.
- Kooti W, Servatyari K, Behzadifar M, Asadi-Samani M, Sadeghi F, et al. (2017) Effective medicinal plant in cancer treatment, Part 2: Review study. Evid-Based Complement Altern Med 22(4): 982-995.
- Kotta S, Ansari SH, Ali J (2013) Exploring scientifically proven herbal aphrodisiacs. Pharmacogn Rev 7(13):1-10.
- Shirani M, Raeisi R, Heidari-Soureshjani S, Asadi-Samani M, Luther T (2017) A review for discovering hepatoprotective herbal drugs with least side effects on kidney. J Nephropharmacol 6(2): 38-48.
- Silve NCC, Fernandes Jr A (2010) Biological properties of medicinal plants: a review of their antimicrobial activity. J Venom Anim Toxins incl Trop Dis 16(3): 402-413.
- Bais SK, Chandewar AV, Charjan SM, Wargantiwar DW (2015) Comparative evaluation microbiological qualities of Ashwagandha formulations marketed in Yavatmal district of India. SOJ Pharm Pharm Sci 2(3): 1-3.
- Silveira D, Prieto-Garcia JM, Boylan F, Estrada O, Fonseca-Bazzo YM, et al. (2020) COVID-19: Is there evidence for the use of herbal medicines as adjuvant symptomatic therapy? Front Pharmacol 11: 581840.
- Safa O, Hassani-Azad M, Farashahinejad M, Davoodian P, Dadvand H, et al. (2020) Effects of Licorice on clinical symptoms and laboratory signs in moderately ill patients with pneumonia from COVID-19: A structured summary of a study protocol for a randomized controlled trial. Trials 21(1): 790.






























